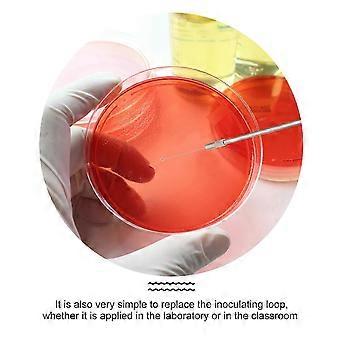
product image

1 Set Biological Experiment Inoculation Rod Laboratory Tool for Bacterial Tw
+ ₹476.99 शिपिंग

1 Set Biological Experiment Inoculation Rod Laboratory Tool for Bacterial Tw
- ब्रांड: Unbranded
1 Set Biological Experiment Inoculation Rod Laboratory Tool for Bacterial Tw
- ब्रांड: Unbranded
बचत करें ₹1,100.00 (50%)
RRP
14-दिन की रिटर्न पॉलिसी
बचत करें ₹1,100.00 (50%)
RRP
14-दिन की रिटर्न पॉलिसी
पेमेंट के तरीके:
विवरण
1 Set Biological Experiment Inoculation Rod Laboratory Tool for Bacterial Tw
- ब्रांड: Unbranded
- श्रेणी: विज्ञान और अन्वेषण सेट
- Fruugo ID: 353888975-769988976
- EAN: 6622139326727
उत्पाद सुरक्षा जानकारी
कृपया नीचे दी गई इस उत्पाद से संबंधित विशिष्ट उत्पाद सुरक्षा जानकारी देखें
निम्नलिखित जानकारी इस उत्पाद को बेचने वाले स्वतंत्र तृतीय-पक्ष खुदरा विक्रेता द्वारा प्रदान की गई है।
उत्पाद सुरक्षा लेबल

डिलीवरी और वापसी
24 घंटों के भीतर भेजा जाएगा
-
STANDARD: ₹476.99 - के बीच वितरण शुक्र 06 फ़रवरी 2026–मंगल 24 फ़रवरी 2026
चीन से शिप हो रहा है।
हम आपके द्वारा ऑर्डर किए गए उत्पादों को पूरी तरह से और आपके विनिर्देशों के अनुसार डिलीवर करने की पूरी कोशिश करते हैं। हालाँकि, यदि आपको अधूरा ऑर्डर या आपके ऑर्डर से कोई अलग आइटम प्राप्त होता है या किसी अन्य कारण से यदि आप अपने ऑर्डर से संतुष्ट नहीं हैं तो आप ऑर्डर या ऑर्डर में शामिल कोई भी उत्पाद वापस कर सकते हैं और आइटम के लिए पूर्ण रिफ़ंड प्राप्त कर सकते हैं। सम्पूर्ण वापसी पॉलिसी दिखाएँ
उत्पाद अनुपालन विवरण
कृपया नीचे दी गई इस उत्पाद से संबंधित विशिष्ट अनुपालन जानकारी देखें।
निम्नलिखित जानकारी इस उत्पाद को बेचने वाले स्वतंत्र तृतीय-पक्ष खुदरा विक्रेता द्वारा प्रदान की गई है।
निर्माता:
नीचे Fruugo पर बिक्री किए जाने वाले संबंधित उत्पाद निर्माता के संपर्क विवरण की जानकारी संबधी सूचना है।
- Dong Guan Shi Ji Shi Xing Wang Luo Ke Ji You Xian Gong Si
- Dong Guan Shi Ji Shi Xing Wang Luo Ke Ji You Xian Gong Si
- Room 604, Unit 1, Building 1, Huatang Shang Apartment, 37 Yingbin Avenue, Tangxia Town, Dongguan City, Guangdong Province
- Dongguan
- CN
- 523000
- wsbgl001@163.com
- 13433341068
यूरोपीय संघ(EU) में जिम्मेदार व्यक्ति:
नीचे यूरोपीय संघ में जिम्मेदार व्यक्ति की संपर्क जानकारी संबंधी सूचना है। जिम्मेदार व्यक्ति यूरोपीय संघ में स्थित पदनामित आर्थिक ऑपरेटर है जो यूरोपीय संघ में बिक्री किए जाने वाले संबंधित उत्पाद संबंधी अनुपालन दायित्वों के लिए जिम्मेदार है।
- Axitera GmbH
- Axitera GmbH
- Kreuznacher Str. 30, D-60486 Frankfurt am Main, Hessen, Germany
- Frankfurt am Main
- DE
- 60486
- infonoticeeran@gmail.com
- (+49) 6934873848